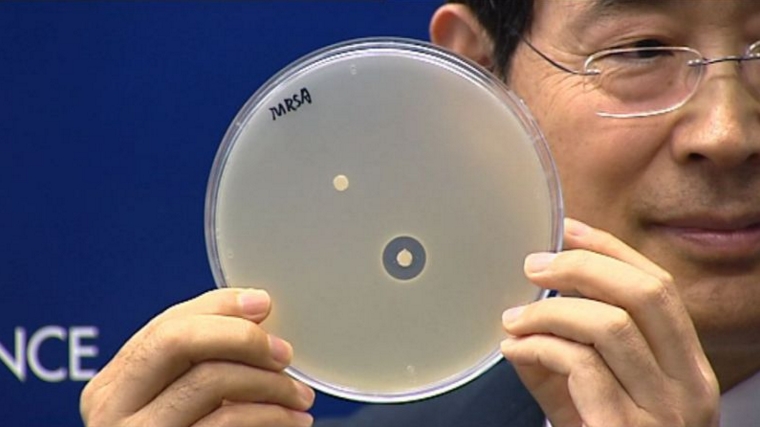

科大發現肽類抗生素耐藥性機制
香港科技大學研究團隊首次發現,細菌對肽類抗生素產生耐藥性的原因,有助藥廠研發新型抗生素對抗超級細菌。
科大研究團隊於2015年開始分析6000多個細菌基因組合,在1200種細菌中發現簡稱DRPs的酵素。
DRPs會識別並分解肽類抗生素內的重要成分,令抗生素失效。肽類抗生素一般被視為最後防線藥物,主要用於治療金黃葡萄球菌和大腸桿菌感染。
研究團隊指,這次研究對研發新型抗生素應付超級細菌有重要作用。
科大發現肽類抗生素耐藥性機制
香港科技大學研究團隊首次發現,細菌對肽類抗生素產生耐藥性的原因,有助藥廠研發新型抗生素對抗超級細菌。
科大研究團隊於2015年開始分析6000多個細菌基因組合,在1200種細菌中發現簡稱DRPs的酵素。
DRPs會識別並分解肽類抗生素內的重要成分,令抗生素失效。肽類抗生素一般被視為最後防線藥物,主要用於治療金黃葡萄球菌和大腸桿菌感染。
研究團隊指,這次研究對研發新型抗生素應付超級細菌有重要作用。
